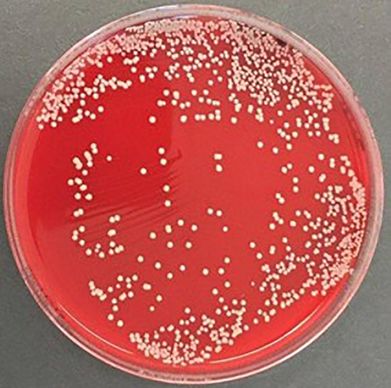

Mammites. La présence de germes antibiorésistants peut expliquer l’échec d’un traitement.
Les mammites sont une problématique majeure en élevage laitier et leur traitement peut souvent virer au casse-tête. Les traitements intra-mammaires ne manquent pas et la méthode de mise en œuvre demande une régularité qui peut être difficile à mettre en place dans les conditions du quotidien.
Prenons l’exemple de plusieurs vaches dans un élevage robotisé, remarquées par l’éleveur car la conductivité augmente fortement depuis quelques jours.Les quartiers concernés ne paraissent pas chauds, rouges, gonflés ou douloureux. À l’examen du lait, cependant, de petites cailles sont visibles.
L’éleveur décide de mettre en place son traitement intra-mammaire à spectre large habituel sur les vaches au fur et à mesure qu’il les diagnostique. La conductivité diminue et le lait reprend un aspect normal. Pourtant, quelques semaines plus tard, le même phénomène se produit sur certaines des vaches déjà traitées et de nouvelles infectées : conductivité augmentée et aspect du lait modifié. C’est lors de cette rechute que l’éleveur doit avoir le réflexe de réaliser une bactériologie chez son vétérinaire. Il s’agit d’un simple prélèvement de quelques millilitres de lait, dans un flacon stérile fourni par le cabinet. Après désinfection du trayon, les premiers jets sont évacués et l’échantillon est prélevé. Il est important de le conserver au réfrigérateur avant de le déposer à la clinique, le plus rapidement possible.
Des tests permettent de révéler l’antibiorésistance
À la clinique, le lait est étalé sur différentes géloses, qui sont ensuite mises en culture pendant vingt-quatre à quarante-huit heures, selon la rapidité de croissance des colonies. Dans notre cas, sur 3 ou 4 prélèvements, un staphylocoque doré (Staphylococcus aureus) a été isolé à chaque fois en quantité modérée à abondante au bout de vingt-quatre heures. Par ailleurs, nous disposons également de tests permettant de mettre en évidence la résistance des bactéries isolées aux bêta-lactamines (une grande famille d’antibiotiques, comprenant notamment les pénicillines). Un résultat positif montre donc que le staphylocoque isolé est résistant aux pénicillines et explique le premier échec de traitement.
Ce résultat nous permet d’adapter le traitement, mais surtout de donner un pronostic à l’éleveur.
Ici, la résistance aux pénicillines explique l’échec du premier traitement intra-mammaire. Nous choisissons donc une autre molécule, associée à un antibiotique par voie générale, autre qu’une pénicilline. Le tarissement, de quelques semaines à quelques mois plus tard en fonction des vaches, a aussi été adapté en choisissant d’autres intra-mammaires et antibiotiques injectables.
Trois mois plus tard, nous faisons le point : certaines vaches ne sont pas remontées en cellules , contrairement à d’autres. Ce résultat en demi-teinte permet de tirer deux conclusions. Les vaches qui ont rechuté sont très probablement infectées chroniques, le traitement est malheureusement illusoire. La réforme est dans ce cas la seule option. Cette décision, radicale et difficile à prendre, reste confirmée avec les dernières études en date : un staphylocoque doré multirésistant condamne la carrière de la vache laitière. En revanche, pour les vaches « guéries » sur le long terme, notre option de traitement a été la bonne.
Toutefois, il faut rester vigilant : les staphylocoques sont des germes contagieux, qui peuvent se transmettre d’une vache à une autre au moment de la traite ou dans le robot si le nettoyage de celui-ci dysfonctionne. Compte tenu de l’importance de l’impact économique en cas de réforme, l’hygiène doit être d’autant plus prise au sérieux.
La bactériologie du lait est un examen très facile à mettre en place, que la plupart des cliniques et cabinets vétérinaires proposent. Pour les non-équipés, les prélèvements peuvent être envoyés au laboratoire départemental, les délais étant sensiblement les mêmes. Le coût, relativement faible, est largement compensé par les économies de traitement réalisées, le lait gagné et le taux de guérison de la vache.

Les anomalies génétiques qui impactent le troupeau laitier français
Le Herd-Book Charolais propose un outil pour prévoir la longévité des vaches
Les élevages bovin viande bio rentables, malgré seulement 0,05 €/kg de plus qu’en conventionnel
« Nous avons investi 1,1 M€ pour avoir une vie normale »
Les députés adoptent une série d'amendements attendus par les agriculteurs
L'Union européenne veut renforcer le soutien aux jeunes agriculteurs
Savencia et Eurial réduisent ensemble leur empreinte carbone
Forte tension sur les engrais azotés : les prix flambent en Europe
Qui sont les gagnants et les perdants de la Pac 2023-2027 ?
Comment inciter les éleveurs à se lancer en bio ?